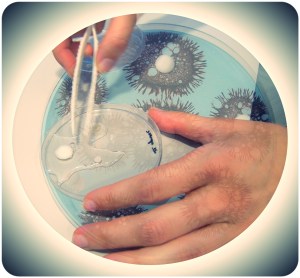
Hidratando o material híbrido para cartilaxes

Joana Magalhães amosoume parte do seu traballo no Instituto de Investigación Biomédica d’A Coruña. Estas son algunhas das fotos que lle tirei montadas sobre imaxes de cultivos e tal e como quedaron dentro das placas Petri.
- Placas Petri con fotografías e fragmentos do poema [in vivo], E…E

![Placas Petri con fotografías e fragmentos do poema [in vivo]](https://estibalizespinosa.com/wp-content/uploads/2013/06/joana-cultivada-2.jpg?w=692&h=700)
Unha opinión sobre “Joana in vivo {2}”